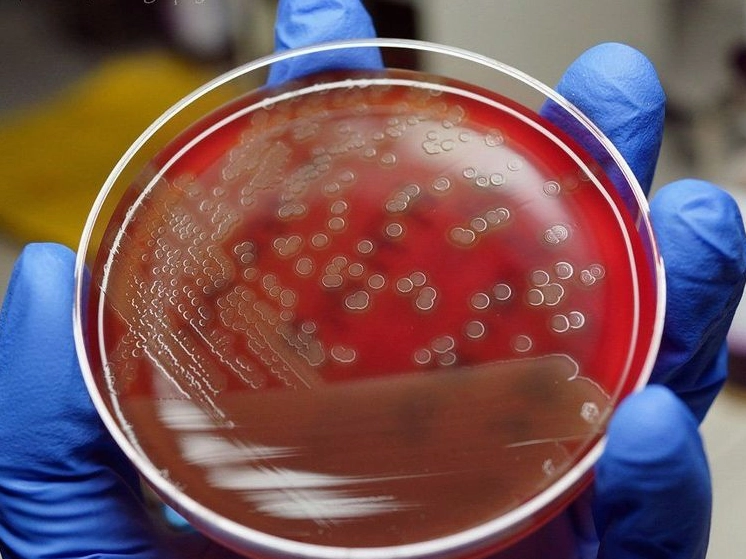
Nhuộm gram có thể xác định được loại vi khuẩn gram âm hay gram dương nhanh hơn phương pháp nuôi cấy

Giải thích chi tiết khái niệm Gram là gì và vai trò quan trọng
Tìm hiểu chi tiết khái niệm Gram là gì, kỹ thuật nhuộm gram là gì và cách phân biệt vi khuẩn gram âm. Khám phá ngay để nắm vững kiến thức y sinh cơ bản!
Trong đời sống hàng ngày cũng như trong các lĩnh vực khoa học, y tế, thuật ngữ Gram xuất hiện rất thường xuyên. Chắc hẳn bạn đã từng nghe đến đơn vị đo lường gram hoặc thắc mắc Gram là gì trong các xét nghiệm y khoa. Bài viết này sẽ giúp bạn hiểu rõ từng khía cạnh của khái niệm này một cách dễ hiểu nhất.

Khái quát về đơn vị đo lường Gram trong vật lý và đời sống
Gram (ký hiệu là g) là một đơn vị đo khối lượng thuộc hệ đo lường quốc tế SI. Theo định nghĩa chuẩn, một gram tương đương với một phần nghìn của một kilôgam (1g = 0.001kg). Đây là đơn vị cực kỳ phổ biến để cân đo các vật thể có khối lượng nhỏ.
Trong ẩm thực, dược phẩm hay chế tác kim hoàn, người ta thường dùng gram để định lượng chính xác các thành phần. Nếu bạn từng thắc mắc Gram là gì trong đo lường, thì nó chính là thước đo tiêu chuẩn cho sự tỉ mỉ.

Bên cạnh đó, trong lĩnh vực tài chính, đôi khi người ta nhầm lẫn thuật ngữ này với các dịch vụ chuyển tiền. Vậy money gram là gì? Đó thực chất là tên một công ty cung cấp dịch vụ chuyển tiền quốc tế nổi tiếng thế giới, không liên quan đến đơn vị đo lường hay y học.

Định nghĩa kỹ thuật nhuộm gram là gì trong y học và sinh học
Bước sang lĩnh vực y học và vi sinh vật học, thuật ngữ Gram lại mang một ý nghĩa hoàn toàn khác. Kỹ thuật nhuộm gram là gì? Đây là một phương pháp nhuộm màu thực nghiệm dùng để phân biệt các loài vi khuẩn thành hai nhóm lớn dựa trên cấu tạo thành tế bào của chúng.
Phương pháp này được phát minh bởi nhà vi khuẩn học người Đan Mạch tên là Hans Christian Gram vào năm 1884. Kể từ đó, đây trở thành kỹ thuật tiêu chuẩn và không thể thiếu trong các phòng thí nghiệm vi sinh để định danh vi khuẩn ban đầu.
Sự khác biệt giữa vi khuẩn Gram âm và Gram dương
Mục đích chính của phương pháp nhuộm là phân chia vi khuẩn thành hai loại đặc trưng. Khi nhuộm xong và quan sát dưới kính hiển vi, vi khuẩn sẽ bắt màu khác nhau.
Vi khuẩn Gram dương có lớp peptidoglycan dày trong thành tế bào, nên giữ lại được màu tím của thuốc nhuộm tinh thể tím (crystal violet). Vậy vi khuẩn gram âm là gì? Đó là những vi khuẩn có lớp peptidoglycan mỏng hơn và có màng ngoài chứa lipopolysaccharide.

Vì cấu trúc này, vi khuẩn gram âm không giữ được màu tím khi bị tẩy bằng cồn, mà sẽ bắt màu đỏ hoặc hồng của thuốc nhuộm bổ sung (safranin). Việc nhận biết này có ý nghĩa sống còn trong việc lựa chọn kháng sinh điều trị.

Quy trình thực hiện kỹ thuật nhuộm Gram cơ bản trong phòng thí nghiệm
Để thực hiện thành công, kỹ thuật viên cần tuân thủ một quy trình gồm bốn bước cơ bản. Mỗi bước đều đóng vai trò quan trọng để đảm bảo kết quả chính xác. Đây là điều Bạn cần biết nếu muốn tìm hiểu sâu về vi sinh học.
Đầu tiên, cố định vi khuẩn lên tiêu bản và nhuộm bằng thuốc nhuộm tinh thể tím. Tiếp theo, sử dụng dung dịch iod để tạo phức hợp gắn chặt màu vào thành tế bào vi khuẩn.

Bước thứ ba là quan trọng nhất: tẩy màu bằng cồn hoặc acetone. Cuối cùng, nhuộm lại bằng safranin hoặc fuchsine để làm hiện rõ các vi khuẩn đã bị mất màu ở bước trước.

Vai trò và ý nghĩa của việc xác định vi khuẩn bằng nhuộm Gram
Trong thực hành lâm sàng, việc xác định nhanh chóng tác nhân gây bệnh là cực kỳ cấp thiết. Nhuộm Gram cho kết quả nhanh hơn rất nhiều so với phương pháp nuôi cấy vi khuẩn truyền thống.
Nhờ kết quả này, bác sĩ có thể định hướng phác đồ điều trị ban đầu và lựa chọn loại kháng sinh phù hợp. Vi khuẩn gram âm thường kháng thuốc mạnh hơn do lớp màng ngoài bảo vệ phức tạp của chúng.

Những lưu ý quan trọng khi tiến hành đánh giá kết quả
Mặc dù rất hữu ích, kỹ thuật này vẫn có những hạn chế nhất định. Không phải tất cả các loại vi khuẩn đều có thể nhuộm bằng phương pháp này. Ví dụ như vi khuẩn lao (Mycobacterium) cần một phương pháp nhuộm đặc biệt khác.
Ngoài ra, tuổi của vi khuẩn, kỹ thuật cố định mẫu, hay thời gian tẩy màu cũng có thể làm sai lệch kết quả. Do đó, kỹ năng của người thực hiện đóng vai trò then chốt.

Tổng kết về khái niệm Gram và các ứng dụng thực tiễn
Như vậy, tùy thuộc vào ngữ cảnh, Gram có thể mang ý nghĩa về khối lượng hay một phương pháp vi sinh. Để có cái nhìn toàn diện, bạn có thể tham khảo thêm nhiều thông tin hữu ích tại Trang chủ của chúng tôi.
Hiểu rõ các thuật ngữ này không chỉ giúp bạn trau dồi kiến thức mà còn ứng dụng tốt trong công việc và việc bảo vệ sức khỏe bản thân.

Bài Viết Liên Quan
Mắt Biếc – Chuyên gia săn lùng ảnh độc lạ, hot nhất! Với con mắt tinh tường, Mắt Biếc không ngừng khám phá, sưu tầm những khoảnh khắc đặc sắc, từ nghệ thuật đến xu hướng viral. Nếu bạn đam mê cái đẹp, hãy theo dõi để không bỏ lỡ những bức ảnh ấn tượng!